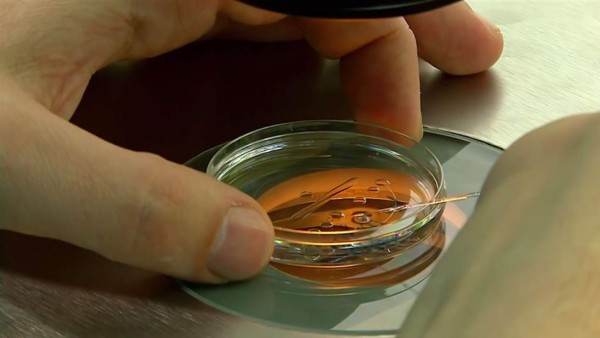
Médico ucraniano, pionero en concepción de bebés con tres padres

Valeri Zukin es el primer médico en usar un polémico método de fertilidad: la concepción de un bebé “con tres padres”.
En el procedimiento, el ovocito de la mujer es fecundado con los espermatozoides de su pareja. Los médicos extraen su núcleo para introducirlo en otro ovocito de una donante, al que ya se le extrajo el núcleo, que es el que contiene el material genético. Así, el ovocito resultante contiene genes de la pareja y alrededor del 0,15% del ADN de la donante, por lo que se considera que tiene “tres padres”.
 Foto captura video de AFP.
|
La iglesia ortodoxa ucraniana asegura que la presencia de un tercer ADN viola la santidad del matrimonio. La católica romana lo rechaza porque implica la destrucción de embriones y la anglicana porque no se ha profundizado lo suficiente en temas éticos.
Esta vez, la comunidad científica también tiene sus dudas y llama a no hablar de un uso amplio hasta vigilar la salud de los recién nacidos al menos hasta sus tres años. Otros estiman que el método debe restringirse a parejas expuestas a transmitir enfermedades genéticas. Texto, foto y video de AFP.
| Foto captura video de AFP.
|